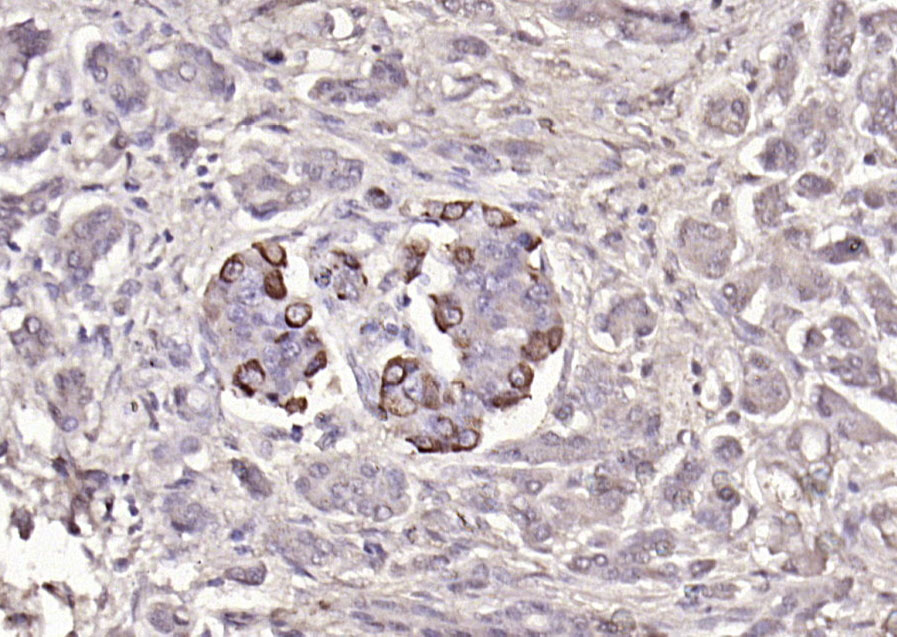
bs-0933R_15

超越单一采购:如何构建高性价比ZO-1抗体/GLP-1抗体/二抗供应体系——以博奥森为例看整体解决方案
在生命科学的广阔领域中,细胞连接与屏障功能的研究一直是核心课题之一。ZO-1抗体(紧密连接蛋白-1)作为维持细胞间紧密连接完整性和屏障功能的关键蛋白,在这一研究领域中扮演着举足轻重的角色。北京博奥森生物技术有限公司凭借其卓越的研发能力和严格的质量控制,推出的高品质ZO-1抗体产品,为科研人员提供了可靠的研究工具。
ZO-1抗体的重要性
ZO-1蛋白广泛表达于上皮和内皮细胞中,是细胞间紧密连接的核心组成部分。它不仅在维持细胞极性方面发挥关键作用,还参与调控屏障功能以及信号转导过程。在肠道屏障功能、血脑屏障、肿瘤转移及炎症性疾病等研究中,ZO-1蛋白的表达和功能变化直接关系到疾病的发病机制和进展。因此,拥有一款高特异性、高灵敏度的ZO-1抗体对于深入研究这些生理和病理过程至关重要。
博奥森ZO-1抗体的优势
博奥森生物技术有限公司提供的ZO-1抗体产品,包括明星产品bs-1329R和bsm-41327R,凭借其卓越的性能在科研界赢得了广泛赞誉。
高特异性:博奥森的ZO-1抗体经过严格的筛选和验证,能够准确识别ZO-1蛋白,避免非特异性结合,确保实验结果的准确性。
高灵敏度:该抗体具有极高的灵敏度,即使在低表达量的样本中也能有效检测到ZO-1蛋白,为科研人员提供了更多的实验可能性。
优异的批间一致性:博奥森采用先进的生产工艺和质量控制体系,确保每一批次的抗体产品都具有高度的一致性,减少了实验中的变异性和不确定性。
广泛的应用场景:博奥森的ZO-1抗体可广泛应用于免疫组化、免疫荧光、Western Blot等多种实验场景,满足不同科研需求。
实际应用案例
在肠道屏障功能的研究中,科研人员常常面临抗体特异性不佳、信号弱、重复性差等痛点。博奥森的ZO-1抗体凭借其卓越的性能,有效解决了这些问题。例如,某研究团队在使用博奥森ZO-1抗体进行肠道组织免疫组化实验时,发现该抗体能够清晰显示ZO-1蛋白在肠道上皮细胞间的分布,且信号强、背景低,为深入研究肠道屏障功能提供了有力支持。此外,该抗体已被300余篇文献引用,充分证明了其在科研领域的广泛应用和认可。
技术支持与整体供应方案
博奥森生物技术有限公司不仅提供高品质的抗体产品,还为客户提供全方位的技术支持和整体供应方案。公司拥有一支资深的科学家团队,能够为客户提供专业的技术咨询和实验指导。同时,博奥森还提供抗体定制服务、标记服务、纯化服务等多种增值服务,满足客户多样化的科研需求。在整体供应方案方面,博奥森凭借其强大的生产能力和完善的物流体系,确保客户能够及时获得所需产品,为科研工作的顺利进行提供有力保障。
性价比与品牌推荐
在科研试剂市场中,性价比是客户选择产品时的重要考虑因素之一。博奥森的ZO-1抗体产品以其卓越的性能和合理的价格赢得了广大客户的青睐。与同类产品相比,博奥森的抗体在保持高品质的同时,价格更具竞争力,为客户节省了科研成本。此外,博奥森作为国内知名的生物试剂品牌,凭借其多年的技术积累和良好的市场口碑,已成为众多科研人员的首选品牌。
北京博奥森提供:流式抗体、内参抗体、标签抗体、标记抗体、ZO-1抗体、GLP-1抗体、二抗、神经退行性疾病重组抗体、细胞凋亡抗体、重组兔单抗、AGES抗体、AD7c-NTP抗体、Ki67抗体、抗体试用装、科学之旅抗体试用装、TSA酪胺信号放大技术等相关产品及服务。
博奥森生物技术有限公司的ZO-1抗体产品以其高特异性、高灵敏度、优异的批间一致性以及广泛的应用场景,在细胞连接与屏障功能研究中发挥了重要作用。公司凭借其强大的技术支持和整体供应方案,为客户提供了一站式的科研服务。同时,博奥森的抗体产品以其卓越的性价比和良好的品牌口碑,赢得了广大客户的信赖和支持。未来,博奥森将继续秉承“为科研工作提供最好服务”的创立初衷,不断创新和突破,为生命科学领域的研究贡献更多力量。
北京博奥森生物技术有限公司
公司官网:https://www.biosschina.com/
订购专线: 400-901-9800


 浙公网安备 33010602011771号
浙公网安备 33010602011771号